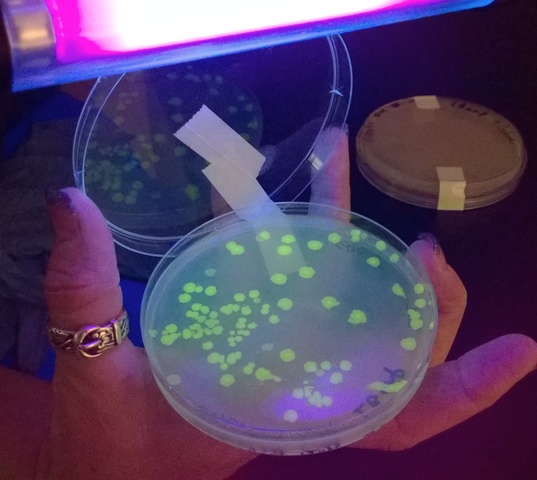
Ecosystems Need Microrganisms

-
Borth ZooAnimals eat and shed organic material that supports microscopic life. Animals need sources of energy to stay alive and healthy. The energy that supports animal life comes from other animals. The srong eats the weak. Many animals have developed special skills that hels them hunt for food and special skills that help them to escape from being eaten. The zoo park is a fun way to see animals that otherwise would be hard to see in our environment.
-
Beautiful PollinatorsMany Insects are pollinators that help plants reproduce prolonging plant life on Earth. Insects like the honey bee drinks nectar from flowers and use it to make honey, an excellent source of energy for humans. Bees are responsible for the survival of thirty percent of our vegetables we eat. Many insects and birds are also pollinators. They too contribute to our survival.
-
Guadalupe RiverFish need water the same way we need air to breath. All life is supported by water. Without clean water ecosystems are destroyed. Rivers support an enourmous number of organisms starting with the one who live in the water and those that depend on it as a source of hydration. Trees need water to live and provide refuge for many species of animals too like birds, insects, bears and wolves to name just a few.
-
Clean Air CrewA big part of organisms on Earth need air to survive. We need to protect the air by avoiding sources of contamination like smog. Every day we breath hundreds if not thousands of time. The quality of the air we breath will determine what kind of life quality we live. The more clean air the better for our lungs and other organs. Air is an essential part of an ecosystem.
-
What is an EcosystemPeople young and old alike need all the parts of an ecosystem to stay alive and healthy. People have developed an ecosystem in which we have farms to raise animals and cultivate plants for food. We are part of a huge ecosystem called Nature.
-
Microorganisms
Microorganisms help us to decompose organic waste.
Want to make a timeline like this?
Use Timetoast to turn dates, events, milestones, and phases into a clear visual timeline you can build and share. Timetoast is a timeline maker for work, school, research, and stories.